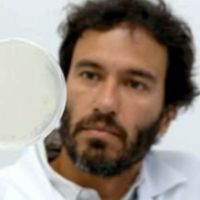

EMPOWERING RESEARCHERS
Leading provider of Life Science Instrumentation and Cardiovascular Research Instruments.
As a company of scientists, IonOptix is committed to supporting preclinical researchers around the world on their quest to better understand cellular and tissue mechanics, cardiovascular function and related disease. We specialize in precision life science instrumentation optimized for studying isolated cardiomyocytes, muscle tissue, blood vessels and tissue culture.
View our full product range here.

IonOptix continues to innovate in a way that helps to drive better science. As well as this, I have always received excellent personal attention from them.

My experience with IonOptix started some years ago when I was a postdoc in US and used the system for measuring cardiomyocyte contractility and calcium transients. I quickly learned to use the system and the software was very user friendly. The results were robust and nicely supported our study. I now have the new system in my lab in Italy and have noticed the ease by which students and postdocs have learned to use it. An additional plus is the technical support people, who always manage, also at short notice, to solve any issue we run into.

After struggling with several other systems over the past few years, our lab purchased an IonOptix Myocyte Calcium and Contractility system and we could not be happier with the equipment. The system and software are not only robust and dynamic, but also straightforward and easy to use. Beyond the system itself, the support staff at IonOptix is incredible. They worked hard with us up front to build the best system for our needs, spent several days on site installing the equipment and training us…
We bought a calcium and contractility recording system a couple of years ago. The system is very robust and works pretty well. We have been doing several measurements in different cells such as adult cardiac myocytes, neonatal cardiac myocytes and human IPS cell-derived cardiomyocytes.

I have worked with the IonOptix system and analytical software since 2010. Both the system and software are intuitive to use and are easily picked up by graduate students and postdocs with little prior knowledge. Most importantly, IonOptix customer support is excellent, including on-site training and assistance with new assay development.

We acquired the complete single-cell IonOptix system for cardiomyocytes not so long ago. The system has given us support to collect data from contractility and calcium transient with great precision. Its usage is not complicated. Moreover, one thing as important as the easy handling and precision is the fast customer assistance given by the company representative. It makes all the difference!

When we originally approached Doug Tillotson in 1999 for help with design and implementation of the single cell stretch set-up, we couldn’t have imagined how much value IonOptix would add! Beyond their off-the-shelve products, they are an enthusiastic and knowledgeable partner in custom-made solutions for problems others think of as ‘too hard to tackle’.






